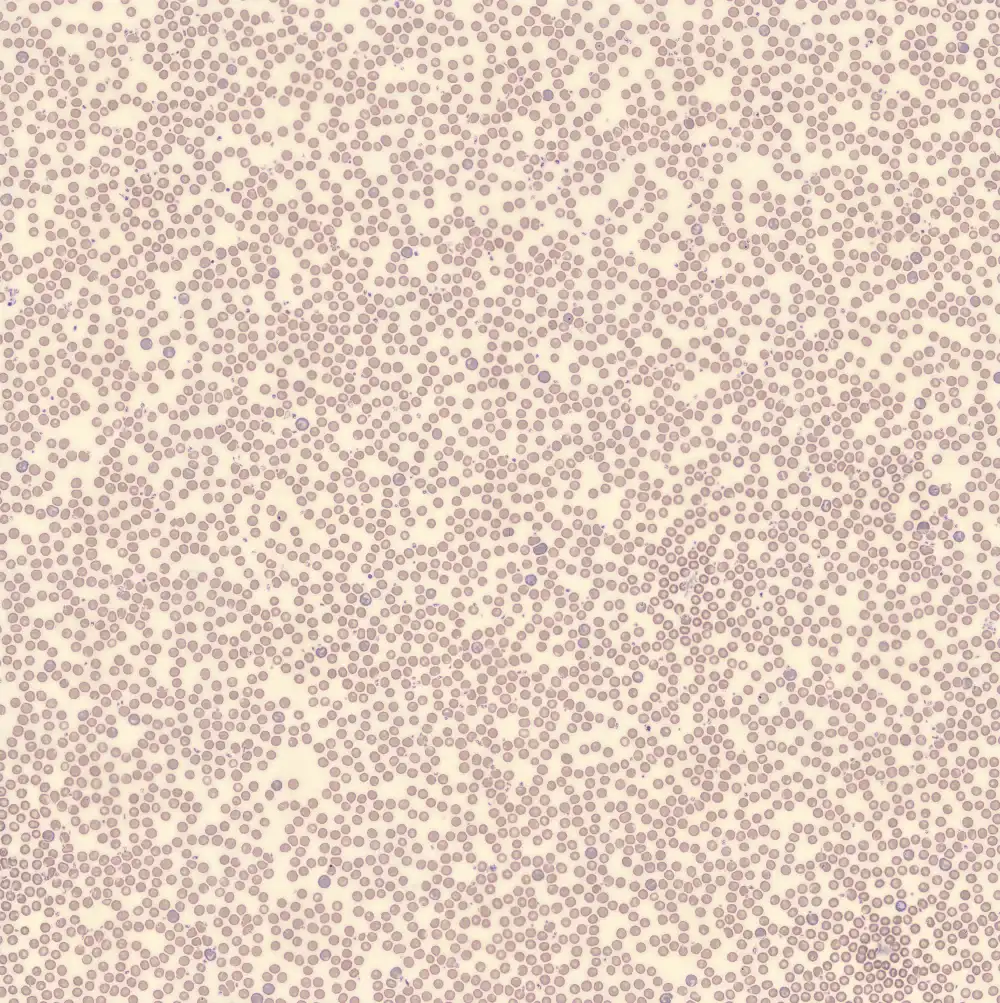

Mouse
The mouse blood smear combines features that would be appropriate in humans for both regeneration and myeloproliferation, with reticulocytosis, pronounced thrombocytosis and a strong lymphocytic differential, complemented by subtly abnormal neutrophils and fragile lymphocytes.
XN Scatterplots
SFL
SSC

Lymphocytes
Monocytes
Neutrophils
Eosinophils
Basophils
Leukocytes
Basophils
NRBCs
Debris
Erythrocytes
Reticulocytes
RBC fragments
Platelets
immature platelets
Lymphocytes
Monocytes
Granulocytes
In the WDF channel, it can be seen that the neutrophils are almost completely huddled up to the lymphocyte population. The eosinophilic granulocytes are also shifted to the left, causing them to be wrongly classifying as neutrophils . In the PLT-F channel, a very large and broad platelet population is visible, indicating a large amount and some variation in size . In the RET channel, reticulocytosis is particularly striking.
Peripheral blood
In the smear, the reticulocytosis as noted in the RET channel is readily apparent; polychrome erythrocytes are plentiful. If you look closely, you can also see some erythrocytes with howell-Jolly bodies.
Thrombocytes



The platelet count is 1065*10^9/L, which is physiological for the mouse. In humans, such values are seen almost exclusively after splenectomy or in myeloproliferative disorders, such as Chronic Myeloid Leukemia, Essential Thrombocytosis or Primary Myelofibrosis. Additionally, the marked variation in shape and size of the platelets is striking.
Neutrophils






Neutrophils are relatively small, hypogranular and show slight hypersegmentation. Some neutrophils have an O-shaped nucleus; this morphology is considered the equivalent of the rod-core neutrophil in humans.
Lymphocytes












Mouse peripheral blood may consist largely (up to about 90%) of lymphocytes. The frequent occurrence of damaged cells is striking. Mouse lymphocytes are fragile and are easily smudged during bloodfilm preparation.
Monocytes



The monocytes exhibit a morphology largely similar to that in humans.
Eosinophils


Eosinophilic granulocytes are also morphologically very similar to those of humans, although the nuclear segmentation may be slightly less pronounced and more alike that of a monocyte.






















